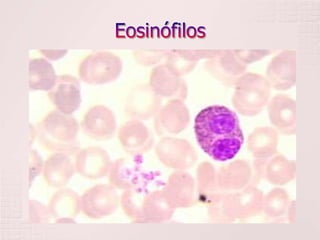

O documento discute o hemograma, que analisa as células do sangue. O hemograma inclui o eritrograma, que estuda os glóbulos vermelhos, e o leucograma, que estuda os glóbulos brancos. O hemograma fornece informações sobre possíveis anemias ou infecções.